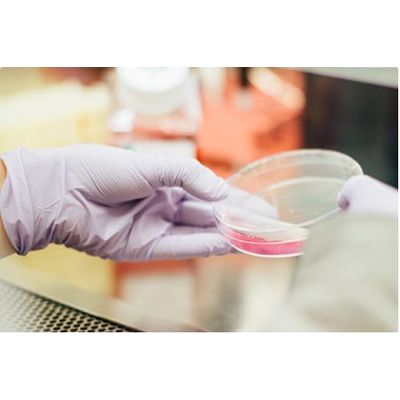

Bioconservacion SA
- Home
- Companies
- Bioconservacion SA
- Services
- Bioconservacion - Application ...
Bioconservacion - Application Consultancy Services
Thanks to our extensive experience we can offer consulting services where we research and advise on products or combinations of products that work specifically for the application being explored.
